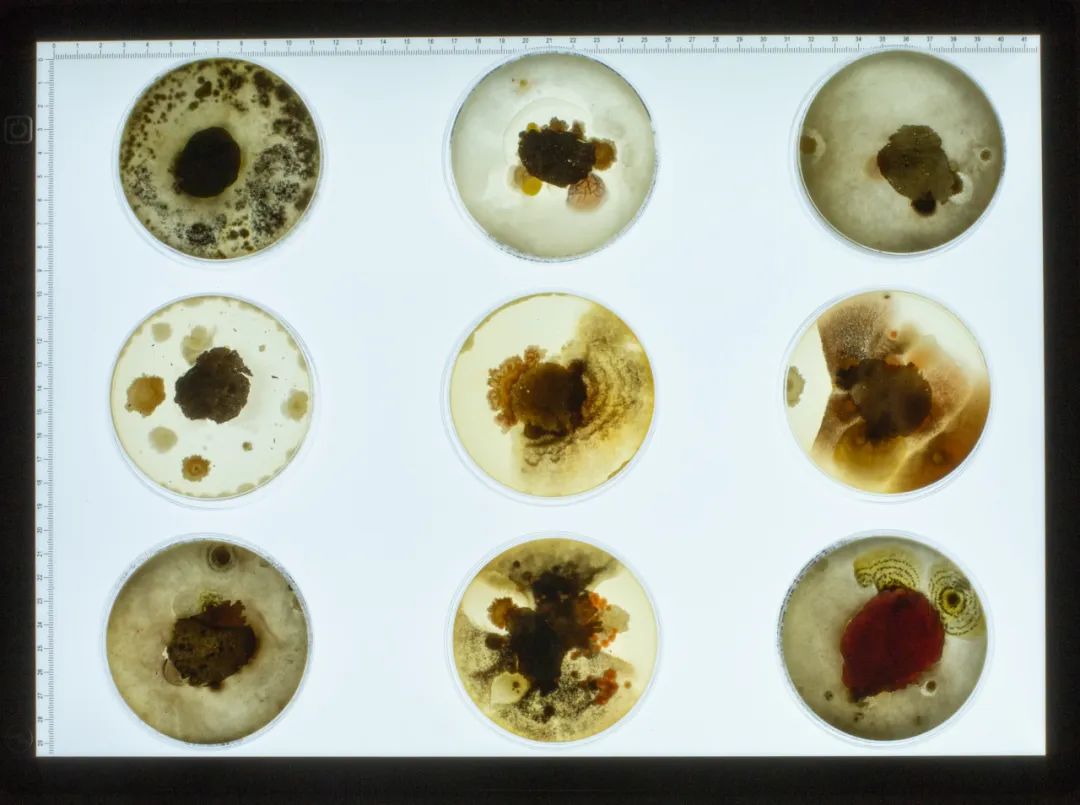

海外傳真 | 安特衛(wèi)普皇家藝術(shù)學(xué)院 2023 MA Design 首飾畢業(yè)作品展
導(dǎo)言
AIVA Gallery
今年畢業(yè)于比利時安特衛(wèi)普皇家藝術(shù)學(xué)院的AIVA海外特派員盧雨曦,為各位讀者介紹該校2023年研究生畢業(yè)展的作品。本次報道中雨曦將結(jié)合采訪問答的形式來幫助大家了解更多創(chuàng)作者的主題概念和創(chuàng)作過程。
Royal Academy of Fine Arts
Antwerp
2023 MA Degree Show

Royal Academy of Fine Arts Antwerp
Jewellery Design & Gold and Silversmithing
珠寶設(shè)計與金銀匠專業(yè)包括
學(xué)術(shù)學(xué)士和碩士學(xué)位課程。
該課程在藝術(shù)工作室實踐、
專業(yè)的和總體的理論支持課程
以及繪畫之間保持健康的平衡,
為學(xué)生的個人藝術(shù)實踐發(fā)展提供支持。
在接下來的4位首飾專業(yè)研究生畢業(yè)作品中,
我們將感受到他們
以其獨特且詩意的視角,
對生命、自然和人類社會展開的關(guān)注與探索,
他們巧妙地融合了不同的媒介,
探討了人類情感、動物權(quán)益、
城市變遷和自然與人造、未來展望等主題,
均散發(fā)著深刻的
人文關(guān)懷和審視現(xiàn)實的勇氣。
MY DEAR
我親愛的
Chanyoung Chang
Ins:@cksckd

展覽現(xiàn)場照片
有時,我們明知不可能實現(xiàn)所期望的結(jié)果,卻仍要為之付出努力。當我們所愛的人走向生命的盡頭時,我們會試圖抓住他們不放。我想主要原因可能是我們不想輕易說再見。然而,在努力留住他們的同時,我們可以慢慢地放空心靈,放下他們(我們所愛的人)。
一朵摘下的百合花、一顆破碎的橡子、一只死去的蝴蝶和老鼠......它們都是我的病人。即使有人說沒有機會治愈它們,我也會抱著希望去實現(xiàn)不可能的事情。

My Dear_ Butterfly(我親愛的蝴蝶)
物件
材料:蝴蝶,繃帶
尺寸:6.3 x 4.3 x 1.5 cm

Armband for a funeral & hospital(葬禮和醫(yī)院的臂環(huán))
袖環(huán)(胸針/手鐲)
材料:繃帶
尺寸:19 x 12 cm

My Dear Rosemary, Freesia(我親愛的迷迭香,小蒼蘭)
物件
材料:繃帶,寶石
尺寸:14.8 x 9.7 x 0.9 cm

展覽現(xiàn)場照片

My Dear_ Lily (我親愛的百合花)
物件
材料:百合、繃帶、寶石
尺寸:123 x 64 x 3 cm


Prosthetic for acorn (給橡果的假體)
胸針/物件
材料:黃銅,丙烯顏料,橡果
尺寸:11.2 x 6 x 3.2 cm


Prosthetic for a blackbird(給烏鴉的假體)
項鏈的掛墜部分/物件
材料:氧化黃銅,銀
尺寸:7.2 x 4.2 x 3.2 cm


Prosthetic for sandwich(給三明治的假體)
項鏈的掛墜部分/物件
材料:3D打印樹脂,銀,三明治
尺寸: 6.1 x 4.4 x 4.3 cm
Q&A
Q:我覺得您的作品充滿了詩意與平靜。您如何描述從開始制作到最終完成作品的過程帶給您的感受?
A:我的作品是關(guān)于嘗試抓住一些已經(jīng)逝去的東西,但最終我需要放手讓他們離去。所以這個過程讓我感覺到被治愈,同時,也是在為我自己舉行了一場葬禮。
<Elegy>
《挽歌》
張可欣
Ins:@zhang_kex

展覽現(xiàn)場照片
在這個系列中,我想質(zhì)疑人類中心主義中扭曲的生命價值,更確切地說,是人類對動物的剝削。通過調(diào)研,我發(fā)現(xiàn)人類基于各種主觀原因賦予動物不同的價值。例如,寵物是珍貴和可愛的,而街上的老鼠則是惡心和毫無價值的。在許多行業(yè)中,人們還根據(jù)是否能從中獲益來衡量動物生命的價值。人們從動物身上取出有價值的部分,然后丟棄無用的部分。我們拿走了血肉和皮毛,卻扔掉了骨頭。
對于這種現(xiàn)象,我感到悲哀和無力。因此,我收集了許多動物的殘骸來形成一種視覺對比。我將這些人們認為無用或反感的部分轉(zhuǎn)化為一種珍貴和悲傷的感覺,以表達我對動物的哀悼和敬意。我想通過這種方式讓人們重新思考對生命價值的定義。

展覽現(xiàn)場照片

第一章
物件
材料: 老鼠骨頭
尺寸:5 x 6 x 19.5cm

展覽現(xiàn)場照片


第二章
物件
材料: 黑貂骨
尺寸: 11 x 7.5 x 19.5cm


第三章
物件
材料: 繭膜,樹枝
尺寸 43.5 x 7 x 12cm

展覽現(xiàn)場照片

第四章
物件
材料: 牛骨,骨粉,骨灰
尺寸: 3~17.5 x 2~6 x 5~13.5 cm

展覽現(xiàn)場照片

第五章
物件
材料: 蛤殼
尺寸:8.5 x 2.5 x 5.5 cm
Q&A
Q:制作過程中的難點是什么?
A:難點的話每種材料都不太一樣。比如小的骨頭需要漂白,但是同時就會變得非常脆弱很難把控。大的骨頭需要打碎然后變成奶油質(zhì)地,那么用什么方式可以讓它的質(zhì)地盡可能的接近奶油就是很困難的地方。再比如蠶繭的薄膜,剛收集來的時候有很多污漬,但是在清理的時候他們又很脆弱只能一遍又一遍的輕柔的處理。
Q:動物肢體材料本身脆弱和不穩(wěn)定感,是否是作品表達的一部分?
A:可以這樣說,因為我是希望就算我的作品的材料是平時被人遺棄的或是忽略的,但是卻可以讓人對它產(chǎn)生一種想要珍惜它的感覺。那么脆弱的材料需要人們更加仔細的去對待去呵護,而且材料本身也有一種破碎感和憂郁感,這是我想要的一種感覺。
Purposeful Accidents
蓄意的偶然
Gabriel? ?lekyt?
Ins:gabojewellery

展覽現(xiàn)場照片
我對在城市和鄉(xiāng)村古老的墻壁非常著迷。我似乎發(fā)現(xiàn)了一扇通向使我與周圍日常生活建立新聯(lián)系的秘密之門。通過捕捉到的圖像,一幅豐富的織錦展現(xiàn)在眼前--逐漸成形的風(fēng)景、世界地圖的碎片、充滿生機的微觀世界、層層疊疊的歷史或人們的故事。每一個都是引人入勝、獨一無二的瞬間。這一切都可以用天氣的條件和時間的流逝來解釋,但對我來說,它們就像是富有表現(xiàn)力的繪畫和個人敘事。

展覽現(xiàn)場照片
我尋找這些獨特的瞬間,并在創(chuàng)作過程中將其表達出來。我嘗試使用濕涂層,逐漸堆疊成新的表面,它們之間不可預(yù)知的相互交疊著。這種直接且即時的創(chuàng)作方法使我能夠詮釋我從偶然形成的墻壁表面中汲取的靈感。在前期不斷增加與后來逐漸消減這些涂層的過程中,材料經(jīng)歷了特定的條件,塑造了物件的特性。在創(chuàng)作過程中不斷出現(xiàn)的問題是,當層數(shù)減少時,作品會顯露出什么。

展覽現(xiàn)場照片
當我在創(chuàng)作過程中發(fā)現(xiàn)一個有意義的結(jié)果時,它立即對我產(chǎn)生了巨大的價值。因此,我必須繼續(xù)探索,并為這種材料的發(fā)展提供空間,使其能夠融入到首飾中,佩戴在身上時能夠得到珍視。通過我的作品,我希望作品中這些被創(chuàng)造出來的層次所帶有的獨特品質(zhì)能夠吸引人們的注意力,喚起人們的好奇心,當時間似乎靜止時,我們可以探索作品的每一部分。

無題
材料:石膏,顏料,蠟,不銹鋼
尺寸:5,5 x 1 x 6,2 cm

無題
材料:石膏,顏料,蠟,不銹鋼
尺寸:5,7 x 2 x 9 cm

無題
材料:石膏,油漆,蠟,不銹鋼,織物網(wǎng)布
尺寸:5,6 x 0,8 x 5,5 cm

無題
材料:石膏,顏料,蠟,不銹鋼
尺寸:1,3 x 2 x 14 cm

無題
材料:石膏,顏料,蠟,不銹鋼
尺寸:7 x 1,5 x 8,7 cm

無題
材料:石膏,顏料,蠟,不銹鋼
尺寸:7,3 x 1,2 x 12 cm
Q&A
Q:在您的研究和制作過程中,最困難的部分是什么? 如何解決?
A:在我的制作過程中最具挑戰(zhàn)性的部分是找到一種方法來揭示材料的層次。展示材料所經(jīng)歷的各個階段非常重要。通過這種方式,將我從城市和鄉(xiāng)村隨著時間的推移而受到影響的舊墻壁中獲取的靈感聯(lián)系起來.
Urban Archeology Lab
城市考古研究所
盧雨曦
Ins:@yuxi__lu

展覽現(xiàn)場照片
城市材料在幾百年后將如何改變?未來的考古學(xué)家將如何看待他們?在快速的科技發(fā)展背景之下,我們是否還能鑒別出它們是自然還是人造之物?
我在安特衛(wèi)普的一個地堡里虛構(gòu)建造了一間城市考古實驗室(建立于2430)邀請觀眾進入這個沉浸式空間來探索未來的考古發(fā)現(xiàn)和檔案。在這里展示的物品反映了21世紀城市生活的碎片。比如:建筑工地的磚塊,超級市場的收據(jù)單,房屋住宅的柵欄以及街道路面的口香糖,這些可識別的物體隨著時間的推移轉(zhuǎn)變?yōu)榫哂兄参铮瑒游锘蚴堑V物特征的生物形態(tài)。
我希望讓觀眾猜測這些物品到底是數(shù)百年自然的產(chǎn)物還是人類與機器操控生成的新物種。提高人們對自然和人類社會現(xiàn)狀的認識,同時激發(fā)觀眾對未來新世界的想象。



展覽現(xiàn)場照片

Bubbling concrete (泡泡水泥)
裝置
材料: 水泥殘垣,沙,玻璃展示盒,燈帶
尺寸: 13 x 6 x 16cm

Crystalized brick (結(jié)晶磚)
裝置
材料:磚塊殘垣,沙,玻璃展示盒,燈帶
尺寸:13 x 6 x 16cm

self-engineering sand Ⅰ(自動成型的沙Ⅰ)
裝置
材料:沙,玻璃展示盒,燈帶
尺寸:13 x 6 x 16cm

Self-engineering sand Ⅱ(自動成型的沙Ⅱ)
裝置
材料:沙,玻璃展示盒,燈帶
尺寸:13 x 6 x 16cm

Crystalized bricks(結(jié)晶磚)
物件
材料:磚塊殘垣,沙
尺寸:可變

Iron flora(鐵卉)
物件
材料:鐵絲網(wǎng),沙,
尺寸:可變

Brick worm (磚蛹)
物件
材料:磚塊殘桓,吸鐵石
尺寸:13 x 3 x 20cm

Fossilized receipt(收據(jù)的化石)
物件
材料:超市收據(jù)單
尺寸:5.5 x 0.5 x 7cm

Urban lichen(城市地衣)
裝置
材料:顯微鏡,化學(xué)器具,口香糖,培養(yǎng)皿,營養(yǎng)瓊脂,發(fā)光板
尺寸:可變
Q&A
Q:有注意到你最終展覽的場地非常特別,可以聊一聊布置細節(jié)嗎?
A:展覽布置花費了很多心思,因為我選的是地窖,給我提供了很大的展覽空間,但那只有一盞燈,十分昏暗。于是我決定干脆就全都暗下來,只照亮作品。一部分“考古碎片”陳列在玻璃桌里,也特意為一部分“保存完好的文物”制作了燈光展示盒,懸掛在墻上。引導(dǎo)觀眾的視線,也給整個空間營造了比較神秘的氛圍。
Q:你最享受的部分是什么?
A:最享受的是不斷試驗材料的過程中偶然出現(xiàn)的讓我很驚喜的效果。同時作品中大部分材料我都是第一次接觸,比如磚塊,沙,收據(jù)單,經(jīng)歷了很多次實驗才逐漸找到合適的處理方法和表達方式。
更多信息歡迎瀏覽官方賬號
ins:
@jewelleryroyalacademyantwerp
@jewellery.ma.academyantwerp
facebook:
Jewellery Design Royal Academy of Fine Arts Antwerp
以上展覽現(xiàn)場照片均由特派員盧雨曦拍攝
盧雨曦
特派員 / Correspondent

盧雨曦,出生于重慶。2019年本科畢業(yè)于四川美術(shù)學(xué)院首飾系,2021-2023就讀于安特衛(wèi)普皇家藝術(shù)學(xué)院珠寶設(shè)計-金匠與銀匠專業(yè), 獲取碩士一等學(xué)位。
喜歡在城市的廢墟里散步
作品網(wǎng)站:https://yuxilu.cargo.site/
Instagram:yuxi__lu

 AIVA公眾號
AIVA公眾號 小紅書:AIVA當代首飾
小紅書:AIVA當代首飾 AIVA當代首飾
AIVA當代首飾 AIVA國際課程中心
AIVA國際課程中心 滬公網(wǎng)安備 31010602004641號
滬公網(wǎng)安備 31010602004641號